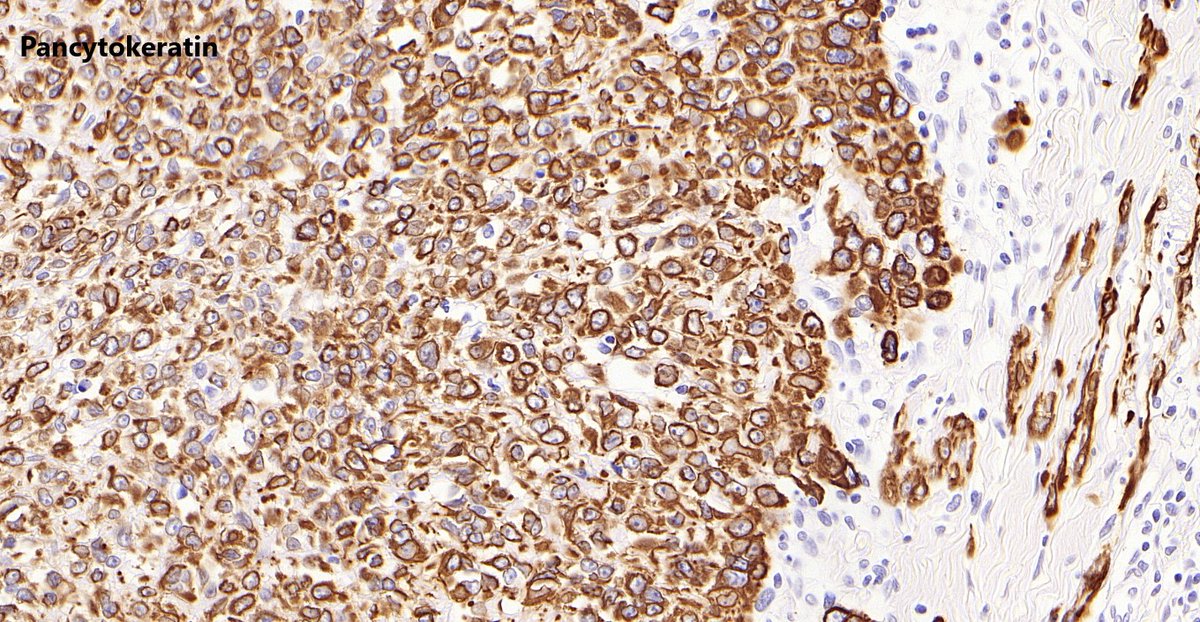
ImmunohistochemistryPositiveCD34NegativeINI-1  (loss of staining)

Question:
Based on the limited history and images, what is your favoured Dx?
Based on the limited history and images, what is your favoured Dx?
Question:
Classically, and clinically, this tumour presents as nodule that is:
Classically, and clinically, this tumour presents as nodule that is:
1/ This sarcoma has a predilection for the distal extremities of younger patients.
2/ This tumour can mimic a granulomatous process, so caution is needed!
3/ It often presents as nonhealing ulcerating nodules, that are painless and slow growing. https://jmedicalcasereports.biomedcentral.com/articles/10.1186/s13256-016-1088-z
2/ This tumour can mimic a granulomatous process, so caution is needed!
3/ It often presents as nonhealing ulcerating nodules, that are painless and slow growing. https://jmedicalcasereports.biomedcentral.com/articles/10.1186/s13256-016-1088-z
Question:
This tumour classically shows loss of INI-1 nuclear expression by IHC:
Complete loss of INI-1 staining is also found commonly in:
This tumour classically shows loss of INI-1 nuclear expression by IHC:
Complete loss of INI-1 staining is also found commonly in:
4a/ Most tumours show complete loss of SMARCB1 (INI1) nuclear protein expression.
4b/ Other tumours that CAN show loss of INI-1 are:
 extraskeletal myxoid chondrosarcoma
extraskeletal myxoid chondrosarcoma
 malignant rhabdoid tumour
malignant rhabdoid tumour
 epithelioid MPNST (~50%) https://www.nature.com/articles/modpathol2012175
epithelioid MPNST (~50%) https://www.nature.com/articles/modpathol2012175
4b/ Other tumours that CAN show loss of INI-1 are:
 extraskeletal myxoid chondrosarcoma
extraskeletal myxoid chondrosarcoma malignant rhabdoid tumour
malignant rhabdoid tumour epithelioid MPNST (~50%) https://www.nature.com/articles/modpathol2012175
epithelioid MPNST (~50%) https://www.nature.com/articles/modpathol2012175
4c/ Interestingly, synovial sarcomas can show reduced expression of INI-1!
5/ There are no proven risk factors or genetic associations. https://www.nature.com/articles/modpathol201071
5/ There are no proven risk factors or genetic associations. https://www.nature.com/articles/modpathol201071
Question:
Which of the following IHC can be positive in these tumours?
Which of the following IHC can be positive in these tumours?
6a/ This tumour is classically positive for the following IHC:
 Most cytokeratins (NB: CK5/6 can be
Most cytokeratins (NB: CK5/6 can be  or focal)
or focal)
 EMA
EMA
 CD34 (~50%+)
CD34 (~50%+)
 Cyclin D1 https://www.nature.com/articles/3800349
Cyclin D1 https://www.nature.com/articles/3800349
 Most cytokeratins (NB: CK5/6 can be
Most cytokeratins (NB: CK5/6 can be  or focal)
or focal) EMA
EMA CD34 (~50%+)
CD34 (~50%+) Cyclin D1 https://www.nature.com/articles/3800349
Cyclin D1 https://www.nature.com/articles/3800349
6b/ Interestingly some studies have shown that CA-125 can be positive both on IHC and elevated in serum. https://pubmed.ncbi.nlm.nih.gov/24475586/
Question:
In regards to the PROXIMAL type of epithelioid sarcoma, which of the following is true:
In regards to the PROXIMAL type of epithelioid sarcoma, which of the following is true:
7a/ Lastly, proximal ES tends to affect older patients but has the same IHC profile (can have a wilder morphology)!
7b/ Both distal & proximal tumours can be for ERG*
for ERG*
(Check out tweet below)
* more common in antibodies that target N-terminus of ERG https://twitter.com/FionaMacPath/status/1306826075708690434?s=20
7b/ Both distal & proximal tumours can be
 for ERG*
for ERG*(Check out tweet below)
* more common in antibodies that target N-terminus of ERG https://twitter.com/FionaMacPath/status/1306826075708690434?s=20

 Read on Twitter
Read on Twitter